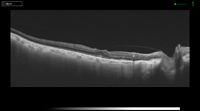
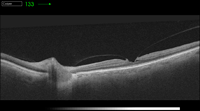
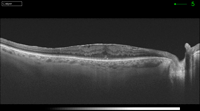
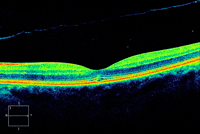

J. Giralt Josa
Introducción
La aparición de la tomografía de coherencia óptica (OCT) ha sido de gran ayuda para valorar la patología macular de la interfase vitreoretiniana. Esta tecnología de imagen ha permitido a los investigadores y a los clínicos estudiar enfermedades que previamente eran irreconocibles de forma no invasiva sólo mediante el examen biomicroscópico
1.
El uso de la OCT ha catalizado la publicación de gran cantidad de artículos que describen las diferentes patologías de la interfase vitreoretiniana, incluyendo el síndrome de tracción vitreomacular (TVM), las membranas epiretinianas (MEM), los agujeros maculares y las esquisis. La reciente introducción de aparatos con mayor resolución de imagen mejora la capacidad de valorar y entender la fisiopatología de estas afecciones
2,3.
Síndrome vitreomacular traccional
El síndrome de TVM es la complicación que se produce cuando hay un desprendimiento posterior del vítreo parcial. El vítreo se separa de la periferia de la retina, pero mantiene su adherencia en la zona macular y en la papila. Este síndrome se acompaña frecuentemente de la presencia de una MEM, que puede tener un papel importante en aumentar la duración y la fuerza de la adherencia residual vitreomacular. En algunas ocasiones puede producirse un desprendimiento de vítreo perifoveolar, con una adherencia pequeña, vitreofoveolar, con una fuerza de tracción anteroposterior más que tangencial, que puede producir un edema macular quístico
4,5.
Las imágenes de OCT son útiles para detectar el desprendimiento posterior de la hialoides, cuando no es visible clínicamente. En el síndrome TVM la hialoides posterior aparece como una imagen hiperreflectiva y engrosada en la OCT
6,7.
Muchos estudios de OCT han documentado que la cirugía para liberar la adherencia vitreofoveolar favorece la resolución del edema o el engrosamiento macular, lo cual la mayoría de las veces se acompaña de una mejora en la agudeza visual en aquellos pacientes que la habían perdido por la TVM. La liberación espontánea del vítreo de la fóvea normalmente tiene los mismos efectos tanto anatómicos como funcionales. En los casos más graves, la TVM puede causar un desprendimiento macular e incluso complicarse con una retinosquisis. También en estos casos se ha demostrado que la cirugía puede mejorar la agudeza visual de estos pacientes.
Yamada y Kishi
8 sugirieron que los patrones de OCT específicos en el preoperatorio del síndrome TVM pueden ser muy útiles para predecir los resultados postoperatorios. Describen dos tipos de patrones de desprendimiento parcial del vítreo posterior. En el primero, hay un desprendimiento del vítreo incompleto a nivel nasal y temporal, produciendo un patrón en “V” por persistir la adherencia en la fóvea. En el segundo tipo de patrón hay una adherencia persistente a nivel nasal con desprendimiento temporal a la fóvea. El primer grupo tuvo mejores resultados postoperatorios que el primero, en relación a la mejoría anatómica y visual
8-12.
A pesar de que se postula que el vector anteroposterior es la fuerza de tracción primaria en el síndrome TVM idiopático, se sugiere que una fuerza tangencial primaria actúa en pacientes con síndrome TVM causado por enfermedades vasculares retinianas como la diabetes o las oclusiones venosas de rama
13-16 (
Figura 1,
Figura 2,
Figura 3,
Figura 4,
Figura 5,
Figura 6 y
Figura 7).

Figura 1. Adhesión vitreomacular.

Figura 2. Tracción vitreomacular.

Figura 3. Tracción vitreofoveolar.
Figura 4. Tracción vitreofoveolar "en meseta".

Figura 5. Liberación de la tracción tras la cirugía de vitrectomía.

Figura 6. Adhesión vitreomacular.
Figura 7. Tracción vitreomacular.
Membrana epiretiniana macular
La OCT se mostrado muy útil para evaluar tanto la morfología como el tratamiento de las MEM. En la OCT casi siempre puede diferenciarse la hialoides posterior de la MEM por tener esta última una reflectividad más gruesa y fuerte
17.
Pueden diferenciarse dos tipos de patrones de adherencia de las MEM. Un patrón sería una adherencia extensa sobre la mácula, y otro, menos frecuente, sería una adherencia focal. En las imágenes de OCT del primer patrón puede apreciarse un borde o margen, y también una imagen de pseudoagujero por aumentar el grosor del contorno foveolar
18,19.
Las MEM también pueden clasificarse, en función de su grosor, en finas (40-60 µm), intermedias (70-100 µm) y gruesas (120-260 µm), y se puede correlacionar la agudeza visual con el grosor macular central obtenido mediante OCT
20.
Las MEM pueden ser idiopáticas o secundarias, con diferentes características en la OCT. Las MEM secundarias se asocian a patologías como desprendimiento de retina, oclusión venosa de rama de la retina, retinopatía diabética, telangiectasias y macroaneurismas. Estas MEM tienen en su mayoría una adherencia de predominio focal, a diferencia de las idiopáticas, que con más frecuencia presentan una adherencia más extensa, no focal. Hay también una asociación entre la adherencia extensa y la presencia de una imagen de pseudoagujero
21.
La OCT también ha sido importante para confirmar la relación entre el desprendimiento posterior del vítreo (DPV) y la MEM. Entre un 10% y un 25% de las MEM idiopáticas crecen en ojos sin DPV.
Johnson publicó un pequeño estudio prospectivo de pacientes con MEM idiopáticas sin evidencia mediante biomicroscopía de la presencia de DPV, mientras que por OCT se demostraba en el 87% de los casos un DPV parcial y en el 13% un DPV completo. Gallemore
et al, encontraron un DPV parcial con adherencia vitreomacular en el 52% de los ojos con MEM evaluados mediante OCT.
La OCT también es muy útil en la evolución natural y en el seguimiento del tratamiento de las MEM. Massin
et al22 demostraron que el grosor macular disminuye después de la cirugía. La arquitectura foveolar puede no volver a su normalidad, pero aun así no se impide que mejore la agudeza visual
22. La resolución espontánea de la MEM también se ha demostrado mediante imágenes secuenciales de OCT. Meyer
et al23 observaron que, en pacientes jóvenes, las fuerzas de contracción de las membranas inmaduras pueden ser más fuertes que sus adherencias a la retina, una condición que favorece su pelado espontáneo
23,24 (
Figura 8,
Figura 9 y
Figura 10).

Figura 8. Pseudoagujero con membrana epiretiniana.
Figura 9. Membrana epiretiniana con engrosamiento macular.

Figura 10. Membrana epiretiniana con tracción foveolar, perdiendo su perfil natural.
Agujero macular
En la clínica, los agujeros maculares de espesor completo (AMEC) pueden confundirse con pseudoquistes, pseudoagujeros y agujeros lamelares (AL). La OCT permite distinguirlos y también ayudar a confirmar la relación entre ellos. La OCT es una herramienta indispensable en el manejo de estos casos. Además, esta técnica de imagen ha capturado la resolución espontánea de estas patologías, ofreciendo una percepción adicional de su fisiopatología
25.
Agujero macular de espesor completo
Hee et al. fueron los primeros en utilizar la OCT para el diagnóstico y el seguimiento de los agujeros maculares. Gaudric
et al28 describen la secuencia de eventos desde la tracción vitreofoveolar anteroposterior hasta el AMEC. Observaron que el desprendimiento de la hialoides posterior se iniciaba en el polo posterior, alrededor de la mácula. Ito
et al. descubrieron que había un desprendimiento perifoveal con tracción foveal persistente en los agujeros en estadio I.
Posteriormente, el desprendimiento se extiende en sentido superior hacia la arcada superior, aumentando las fuerzas tangenciales y progresando a estadio II. Cuando el DPV se extiende temporalmente e inferiormente, se asocia con estadio III. Por último, cuando la hialoides posterior se desprende del nervio óptico, el desprendimiento vítreo se extiende hasta la periferia extrema
26-29.
-
Estadio I: se describe como la disminución o la ausencia de la depresión foveolar. Hay una escisión en la retina interna en los procesos celulares de las células de Muller, producida por una tracción anteroposterior u oblicua ejercida por el desprendimiento vítreo perifoveolar. Esta escisión, también llamado pseudoquiste, se extiende posteriormente para afectar la retina externa, pero manteniendo su techo intacto.
-
Estadio II: cuando la tracción rompe el techo de la retina se clasifica como estadio II. Hay una pequeña pérdida de espesor completo del tejido de la retina, con quistes en sus lados. Este estadio puede subdividirse en:
-
Estadio IIA: agujeros <400 µm con la hialoides posterior adherida al techo de la retina.
-
Estadio IIB: agujeros de <400 µm con opérculo.
El diámetro del agujero macular medido mediante OCT se ha correlacionado con los resultados de la cirugía. Los agujeros pequeños tienen más posibilidades de que se cierren de forma espontánea o con una única cirugía.
-
Estadio III: se trata de un agujero completo, con o sin opérculo, mayor de 400 µm, con la retina que le rodea engrosada e incluyendo espacios quísticos. La hialoides perifoveolar y prefoveolar está desprendida.
-
Estadio IV: es un estadio III con un DPV completo. En estos casos, sólo con OCT de última generación, como el EV de Topcon, puede visualizarse la hialoides posterior, porque está situada muy anterior.
-
Estadio 0: son aquellos pacientes con un AMEC en un ojo mientras que en el ojo contralateral tienen un perfil foveolar normal, pero con adherencia vitreomacular en un lado o en ambos lados de la fóvea. Estos pacientes tienen un riesgo aumentado de desarrollar un AMEC en el ojo contralateral30.
El aumento en los conocimientos sobre el vítreo ha permitido, en diciembre de 2013, que un panel de expertos en la materia elaborara una nueva clasificación. Los principios de esta clasificación se resumen en que es estrictamente anatómica (OCT), basada en síntomas y no en hallazgos clínicos, simple y fácil de usar, y predecir los resultados tanto con cirugía como con vitreólisis farmacológica
31-35. Esta clasificación se divide en tres categorías:
-
Adherencia vitreomacular (VMA).
-
Tracción vitreomacular (VMT).
-
Agujero macular de espesor completo (AMEC).
La VMA se subclasifica en focal (<1.500 µm) o ancha (>1.500 µm), de forma aislada o con otras patologías a la vez, y sin anormalidades en su estructura. La VMT se subclasifica en focal (<1.500 µm) o ancha (>1.500 µm), de forma aislada o asociada a otras patologías, y con anormalidades estructurales en la mácula. El AMEC se subclasifica en pequeño (<250 µm), mediano (>250 µm y <400 µm) y grande (>400 µm), con o sin VMT, y de forma primaria o secundaria a otras patologías
36 (
Tabla 1 y
Figura 11,
Figura 12,
Figura 13,
Figura 14,
Figura 15,
Figura 16,
Figura 17,
Figura 18,
Figura 19,
Figura 20,
Figura 21,
Figura 22,
Figura 23).

Tabla 1.

Figura 11. Agujero macular con tracción vítrea.

Figura 12. Agujero macular estadio I.

Figura 13. Agujero macular en estadio I, al mes de realizar cirugía de vitrectomía.

Figura 14. Agujero macular en estadio I, a los 2 meses de realizar cirugía de vitrectomía.
Figura 15. Agujero macular en estadio I, a los 3 meses de realizar cirugía de vitrectomía.

Figura 16. Agujero macular en estadio IIA.

Figura 17. Agujero macular en estadio IIB, de 208 µm.

Figura 18. Agujero macular en estadio IIB, al mes de realizar cirugía de vitrectomía.

Figura 19. Agujero macular en estadio III.

Figura 20. Agujero macular con tracción vítrea.

Figura 21. Agujero macular mediano o de estadio IIB, de 374 µm.

Figura 22. Agujero macular mediano o de estadio IIB, de 326 µm.

Figura 23. Agujero macular de estadio III, de 459 µm.
Pseudoagujero/agujero lamelar
Ambos son diferentes y con manejos diferentes. Clínicamente se muestran como lesiones ovales o redondeadas rojizas en el centro de la mácula. A diferencia del AMEC, el pseudoagujero (PA) tiene una retina neurosensorial intacta, y todos tienen una MEM. La contracción centrípeta de la MEM es lo que confiere su forma característica al PA. Los AL están en el mismo espectro que los AMEC, pero representan un proceso abortado. La OCT permite diferenciarlos. El PA tiene una pared de la depresión foveolar con más pendiente, sus bordes están engrosados, tiene un diámetro de la depresión foveolar disminuido y un grosor central foveolar normal o ligeramente aumentado. Los AL tienen suelo foveolar irregular y más fino, con los bordes foveolares rotos, con un grosor de la retina perifoveolar casi normal y un grosor foveolar central por debajo de la media.
Con OCT de ultrarresolución puede distinguirse mejor. Los AL muestran un contorno foveolar irregular, una rotura en la fóvea interna, separación entre las capas internas y externas de la fóvea, y ausencia de un defecto de espesor completo con fotorreceptores intactos en la zona posterior a la dehiscencia. También las imágenes demuestran que la gran mayoría (89% según Witkin
et al37) de AL asocian una MEM con un grosor de aspecto algo diferente al habitual. Se cree que estas MEM tienen vítreo atrapado que estabiliza la anatomía de la retina, abortando el proceso hacia un AMEC. A pesar de que hay publicaciones de casos con una mejora anatómica y funcional después de realizar una vitrectomía con gas con éxito, también las hay que no demuestran buenos resultados
37,38 (
Figura 24,
Figura 25,
Figura 26,
Figura 27,
Figura 28,
Figura 29).

Figura 24. Pseudoagujero con membrana epiretiniana.

Figura 25. Pseudoagujero con membrana epiretiniana.

Figura 26. Agujero lamelar con membrana epiretiniana.

Figura 27. Agujero lamelar con membrana epiretiniana.

Figura 28. Membrana epiretiniana con engrosamiento macular y pérdida del perfil foveolar.

Figura 29. Agujero lamelar con membrana epiretiniana.
Maculopatía traccional miópica
Actualmente, con la OCT es posible evaluar las alteraciones de la interfase vitreomacular en ojos con alta miopía. Uno de estos fenómenos es la rotura o esquisis que se produce con frecuencia en ojos con alta miopía y estafiloma posterior. La esquisis es casi imposible de ver en la exploración biomicroscópica. Según los estudios realizados por Benhamou
et al41 en pacientes con alta miopía, con una media de refracción de -15,2 D, existirían dos patrones de esquisis. En el patrón de esquisis externa, la retina se separa en una capa interna gruesa y una capa externa más fina por un espacio ancho hiporreflectivo. En algunos casos pueden apreciarse en la OCT unos puentes lineales que atraviesan este espacio hiporreflectivo. El otro patrón sería de esquisis interna, en la cual la separación de la retina divide una capa interna fina de una capa externa gruesa. El patrón más frecuente es el de esquisis externa, pero con componentes que pueden variar desde esquisis internas y desprendimientos maculares hasta AL o AMEC. También puede detectarse, en algunos casos, adherencia de la hialoides posterior traccionando. La presencia de un estafiloma posterior también es frecuente
39-42.
En conjunto, puede afirmarse que las esquisis son procesos bastante estables, con una progresión lenta. La presencia de una tracción vitreomacular en estos pacientes puede llevar a la formación de AMEC. Un porcentaje pequeño de ellos lo pueden desarrollar de forma asintomática. Esto se correlaciona con la presencia de tejido epiretiniano, el grado de miopía y la juventud del paciente
43,44.
Aunque la naturaleza de la tracción y la importancia de su patogenia en esta enfermedad no se entiende de manera clara, numerosas publicaciones han documentado la mejoría o la resolución de la esquisis miópica tras la vitrectomía con eliminación del vítreo cortical posterior y/o pelado de la membrana limitante interna. También se cree que fuerzas de tracción de la retina hacia el centro de la fóvea a lo largo de las arteriolas pueden estar relacionadas con la patogénesis de las afecciones vitreoretinianas miópicas, incluyendo la retinosquisis y la formación del agujero macular
45,46 (
Figura 30,
Figura 31,
Figura 32,
Figura 33).

Figura 30. Agujero macular miópico, con tracción y esquisis macular.

Figura 31. Agujero macular miópico, con tracción y esquisis macular, al mes de realizar cirugía de vitrectomía.

Figura 32. Agujero macular miópico, con tracción y esquisis macular, a los 6 meses de realizar cirugía de vitrectomía.

Figura 33. Esquisis con tracción en paciente miope con estafiloma posterior.
Conclusiones
La OCT proporciona información esencial para poder valorar la interfase vitreoretiniana. Ha revolucionado la forma en que los síndromes de tracción vitreomacular, las membranas epiretinianas, los agujeros maculares de espesor completo, los pseudoagujeros, los agujeros lamelares y la esquisis macular son diagnosticados y manejados. La OCT en la interfase vitreoretiniana muchas veces puede ser de ayuda para planificar intervenciones quirúrgicas y para proporcionar información del pronóstico postoperatorio. En resumen, esta técnica de imagen no invasiva, de no contacto, es imprescindible en la valoración y en el estudio completo de estas patologías que son difíciles de valorar en la clínica sólo con el examen biomicroscópico.
Bibliografía
-
Jaffe GJ, Caprioli J. Optical coherence tomography to detect and manage retinal disease and glaucoma. Am J Ophthalmol. 2004;137:156-69.
-
Coleman DJ, Silverman RH, Chabi A, et al. High-resolution ultrasonic imaging of the posterior segment. Ophthalmology. 2004;111:1344-51.
-
Drexler W, Sattmann H, Hermann B, et al. Enhanced visualization of macular pathology with the use of ultrahigh-resolution optical coherence tomography. Arch Ophthalmol. 2003;121:695-706.
-
Johnson MW. Perifoveal vitreous detachment and its macular complications. Trans Am Ophthalmol Soc. 2005;103:537-67.
-
Johnson MW. Perifoveal vitreous detachment and its macular complications. Trans Am Ophthalmol Soc. 2005;103:537-67.
-
Smiddy W. Vitreomacular traction syndrome. En: Yanoff N, Duker JS, editors. Ophthalmology, 2nd ed. St. Louis: Mosby; 2004. p. 951-5.
-
Hotta K, Hotta J. Retinoschisis with macular retinal detachment associated with vitreomacular traction syndrome. Retina. 2004;24:307-9.
-
Yamada N, Kishi S. Tomographic features and surgical outcomes of vitreomacular traction syndrome. Am J Ophthalmol. 2005;139:112-7.
-
Benhamou N, Massin P, Haouchine B, et al. Macular retinoschisis in highly myopic eyes. Am J Ophthalmol. 2002;133:794-800.
-
Johnson MW. Tractional cystoid macular edema: a subtle variant of the vitreomacular traction syndrome. Am J Ophthalmol. 2005;140:184-92.
-
Gaucher D, Tadayoni R, Erginay A, et al. Optical coherence tomography assessment of the vitreoretinal relationship in diabetic macular edema. Am J Ophthalmol. 2005;139:807-13.
-
Brancato R. Optical coherence tomography (OCT) in macular edema. Doc Ophthalmol. 1999;97:337-9.
-
Degenring RF, Aschmoneit I, Kamppeter B, et al. Optical coherence tomography and confocal scanning laser tomography for assessment of macular edema. Am J Ophthalmol. 2004;138:354-61.
-
Otani T, Kishi S, Maruyama Y. Patterns of diabetic macular edema with optical coherence tomography. Am J Ophthalmol. 1999;127:688-93.
-
Kang SW, Park CY, Ham DI. The correlation between fluorescein angiographic and optical coherence tomographic features in clinically significant diabetic macular edema. Am J Ophthalmol. 2004;137:313-22.
-
Panozzo G, Parolini B, Gusson E, et al. Diabetic macular edema: an OCT-based classification. Semin Ophthalmol. 2004;19:13-20.
-
Wilkins JR, Puliafito CA, Hee MR, et al. Characterization of epiretinal membranes using optical coherence tomography. Ophthalmology. 1996;103:2142-51.
-
Mori K, Gehlbach PL, Sano A, et al. Comparison of epiretinal membranes of differing pathogenesis using optical coherence tomography. Retina. 2004;24:57-62.
-
Gass J. Stereoscopic atlas of macular diseases diagnosis and treatment. St. Louis: Mosby; 1997. p. 904-51.
-
Heilskov TW, Massicotte SJ, Folk JC. Epiretinal macular membranes in eyes with attached posterior cortical vitreous. Retina. 1996;16:279-84.
-
Wise GN. Clinical features of idiopathic preretinal macular fibrosis. Schoenberg Lecture. Am J Ophthalmol. 1975;79: 349-57.
-
Massin P, Allouch C, Haouchine B, et al. Optical coherence tomography of idiopathic macular epiretinal membranes before and after surgery. Am J Ophthalmol. 2000;130:732-9.
-
Meyer CH, Rodrigues EB, Mennel S, et al. Spontaneous separation of epiretinal membrane in young subjects: personal observations and review of the literature. Graefes Arch Clin Exp Ophthalmol. 2004;242:977-85.
-
Niwa T, Terasaki H, Kondo M, et al. Function and morphology of macula before and after removal of idiopathic epiretinal membrane. Invest Ophthalmol Vis Sci. 2003;44:1652-6.
-
Ansari H, Rodriguez-Coleman H, Langton K, et al. Spontaneous resolution of bilateral stage 1 macular holes documented by optical coherence tomography. Am J Ophthalmol. 2002;134:447-9.
-
Azzolini C, Patelli F, Brancato R. Correlation between optical coherence tomography data and biomicroscopic interpretation of idiopathic macular hole. Am J Ophthalmol. 2001;132:348-55.
-
Fujii GY, De Juan E, Bressler NM. Vitrectomy surgery for impending macular hole based on optical coherence tomography. Retina. 2001;21:389-92.
-
Gaudric A, Haouchine B, Massin P, et al. Macular hole formation: new data provided by optical coherence tomography. Arch Ophthalmol. 1999;117:744-51.
-
Ishida M, Takeuchi S, Okisaka S. Optical coherence tomography images of idiopathic macular holes with spontaneous closure. Retina. 2004;24:625-8.
-
Chan A, Duker JS, Schuman JS, et al. Stage 0 macular holes: observations by optical coherence tomography. Ophthalmology. 2004;111:2027-32.
-
Johnson MW. Improvements in the understanding and treatment of macular hole. Curr Opin Ophthalmol. 2002;13:152-60.
-
Kitchens JW, Flynn HW, Moshfeghi AA, et al. Idiopathic macular hole with extensive subretinal fluid: clinical and optical coherence tomography features before and after surgery. Am J Ophthalmol. 2005;139:383-6.
-
Smiddy WE, Flynn HW. Pathogenesis of macular holes and therapeutic implications. Am J Ophthalmol. 2004;137:525-37.
-
Spaide RF. Macular hole repair with minimal vitrectomy. Retina. 2002;22:183-6.
-
Altaweel M, Ip M. Macular hole: improved understanding of pathogenesis, staging, and management based on optical coherence tomography. Semin Ophthalmol. 2003;18:58-66.
-
Duker JS, Kaiser PK, Binder S, et al. The International Vitreomacular Traction Study Group. Classification of vitreomacular adhesion, traction and macular hole. Ophthalmology. 2013;120(12):2611-9.
-
Witkin AJ, Ko TH, Fujimoto JG, et al. Redefining lamellar holes and the vitreomacular interface: an ultrahigh-resolution optical coherence tomography study. Ophthalmology. 2006;113:388-97.
-
Hirakawa M, Uemura A, Nakano T, et al. Pars plana vitrectomy with gas tamponade for lamellar macular holes. Am J Ophthalmol. 2005;140:1154-5.
-
Coppe AM, Ripandelli G. Optical coherence tomography in the evaluation of vitreoretinal disorders of the macula in highly myopic eyes. Semin Ophthalmol. 2003;18:85-8.
-
Baba T, Hirose A, Kawazoe Y, et al. Optical coherence tomography for retinal detachment with a macular hole in a highly myopic eye. Ophthalmic Surg Lasers Imaging. 2003;34:483-4.
-
Benhamou N, Massin P, Haouchine B, et al. Macular retinoschisis in highly myopic eyes. Am J Ophthalmol. 2002;133:794-800.
-
Coppe AM, Ripandelli G, Parisi V, et al. Prevalence of asymptomatic macular holes in highly myopic eyes. Ophthalmology. 2005;112:2103-9.
-
Akiba J, Konno S, Sato E, et al. Retinal detachment and retinoschisis detected by optical coherence tomography in a myopic eye with a macular hole. Ophthalmic Surg Lasers. 2000;31:240-2.
-
Hirakata A, Hida T. Vitrectomy for myopic posterior retinoschisis or foveal detachment. Jpn J Ophthalmol. 2006;50:53-61.
-
Ikuno Y, Gomi F, Tano Y. Potent retinal arteriolar traction as a possible cause of myopic foveoschisis. Am J Ophthalmol. 2005;139:462-7.
-
Kobayashi H, Kishi S. Vitreous surgery for highly myopic eyes with foveal detachment and retinoschisis. Ophthalmology. 2003;110:1702-7.